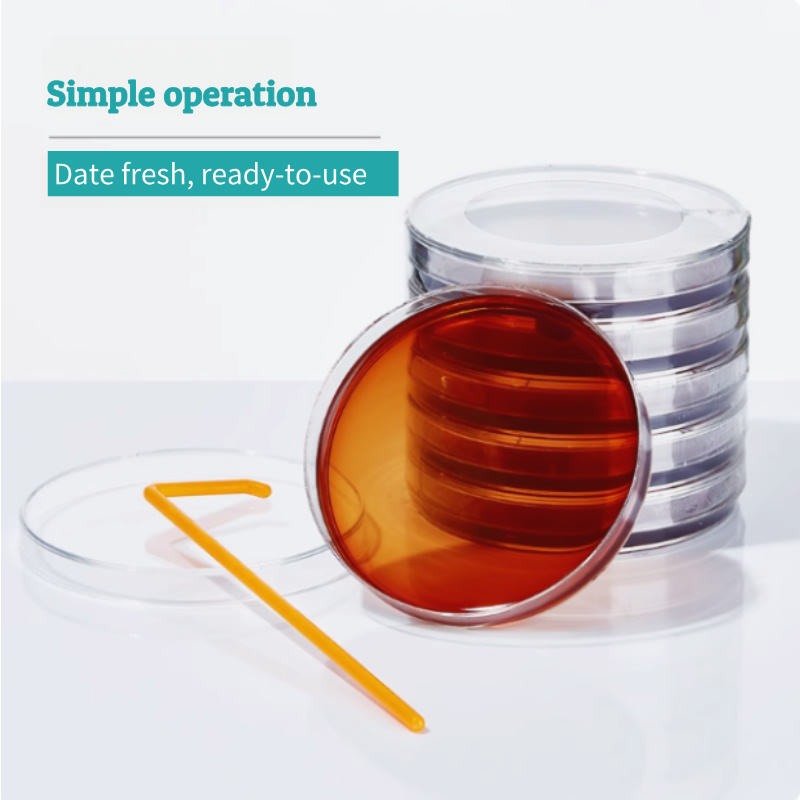

BKMAM Bioagar Plate Set TCBS Vibrio Aqua Plate Nutrient AGAR para suministros de laboratorio de cultivo microbiano bacteriano
Puntuación de la tienda:
2.8
(5 reseñas)

Atributos
Hunan, ChinaLugar del origen
BKMAMMarca
OEM, ODMSoporte personalizado
7-9mmTamaño
1 añoGarantía
110704010Número de Modelo
Nombre del producto:Agar de sangre
Especificación:7-9mm
Embalaje:10 platos/bolsa
Características clave
Lugar del origen
Hunan, China
Marca
BKMAM
Soporte personalizado
OEM, ODM
Tamaño
7-9mm
Garantía
1 año
Número de Modelo
110704010
Nombre del producto
Agar de sangre
Especificación
7-9mm
Embalaje
10 platos/bolsa
Empaque y entrega
Unidades de venta
Artículo individual
Tiempo de entrega
Descripción de producto del proveedor
Cantidad mínima de compra: 5 unidades
EUR 340- 680
Cantidad
Envío
Tarifa de envío y fecha de entrega por definir. Chatea con el proveedor para confirmar los detalles.
Subtotal del artículo
EUR 0.00 - EUR 0.00
Total del envío
Por definir
Total antes de impuestos
EUR 0.00 - EUR 0.00
4 pagos sin intereses con
Protección de pedidos de Alibaba.com
Pagos seguros
Todos tus pagos realizados en Alibaba.com están protegidos por cifrado SSL y protocolos de protección de datos PCI DSS
Devoluciones fáciles
Realiza devoluciones locales gratuitas por defectos en compras elegibles
Garantía de devolución de dinero
Solicita un reembolso si tu pedido no se envía, no llega o hay defectos en el producto














